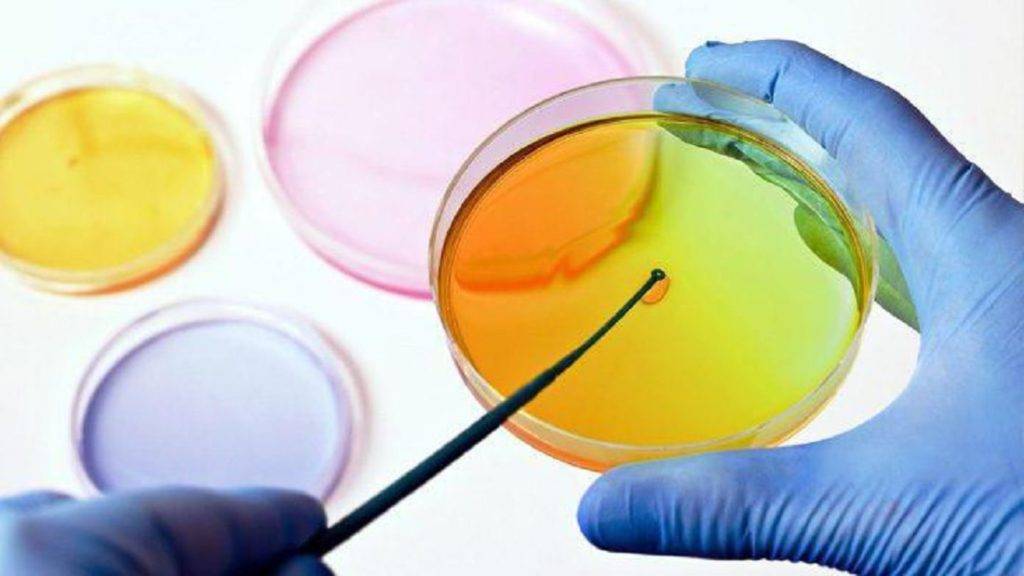

Репеллент и аптека
В нашей стране немало и своих «доморощенных» возбудителей инфекций, передающихся насекомыми. Так что поговорим и о репеллентах. Чаще потребители покупают их в супермаркете или хозяйственном магазине. А почему не в аптеке? Ведь репелленты, по сути, это профилактические средства, защищающие наш организм от патогенных факторов. Если исходить из этого, они должны присутствовать в аптечном ассортименте, тем более что их распыляют на кожу. А вот могут ли они там присутствовать с точки зрения законодательства?
В пункте 7 статьи 55 Закона «Об обращении лекарственных средств» (№ 61‑ФЗ от 12.04.2010) перечислены группы товаров, которые имеют право продавать аптечные организации. Репелленты в этом списке отдельно не упоминаются, но в нем присутствуют «медицинские изделия».
В Общероссийском классификаторе продукции (ОКП) репелленты фигурируют сразу в двух разделах. Во-первых, в разделе 23 0000, где перечислены группы товаров бытовой химии. Здесь репелленты под кодом 23 8620 соседствуют с инсектицидами («средства для борьбы с бытовыми насекомыми») и зооцидами («средства для борьбы с домашними грызунами»).
Репелленты — под другим кодом, ОКП 93 9260 — включены также в раздел 93 0000, носящий название «Медикаменты, химико-фармацевтическая продукция и продукция медицинского назначения». Здесь они находятся в аналогичном соседстве с дезинфицирующими (93 9210), дезинсекционными (93 9220) и дератизационными (93 9230) средствами.
Таким образом, возможность продажи того или иного репеллента в аптеке или аптечном пункте зависит от того, в соответствии с каким из этих кодов он зарегистрирован в Роспотребнадзоре. Если по коду 93 9260, тогда репеллент может быть отнесен к продукции медицинского назначения (медицинским изделиям) и присутствовать в аптечном ассортименте.
Лечение ГЛПС
1) Организационно-режимные мероприятия
• Госпитализация всех больных в стационар, больные не заразны для окружающих, поэтому можно лечить в инфекционных, терапевтических, хирургических стационарах.
• Транспортировка с исключением любых сотрясений.
• Создание щадящего охранительного режима:
1) постельный режим – легкая форма – 1,5-2 недели, ср-тяжелой – 2-3 недели, тяжелой – 3-4 недели.
2) соблюдение диеты – стол № 4 без ограничения белка и соли, негорячая, негрубая пища, питание небольшими порциями часто. Жидкости в достаточном количестве – минеральная вода, Боржоми, Ессентуки № 4, муссы. Морсы, фруктовые соки с водой.
3) ежедневная санация полости рта – р-ром фурациллина (профилактика осложнений), ежедневное опорожнение кишечника, ежедневное измерение суточного диуреза (каждые 3 часа кол-во выпитой и выделенной жидкости).
2) Профилактика осложнений: антибактериальные препараты в обычных дозах (чаще пенициллин)
3) Инфузионная терапия: цель – дезинтоксикация организма и профилактика осложнений. Основные растворы и препараты: концентрированные растворы глюкозы (20-40%) с инсулином с целью энергообеспечения и устранения избытка внеклеточного К, преднизолон, аскорбиновя кислота, глюконат кальция, лазикс по показаниям. При отсутствия эффекта «размачивания» (то есть увеличения диуреза) – назначается дофамин в определенной дозировке, а также для нормализации микроциркуляции – курантил, трентал, эуфиллин.
4) Гемодиализ при тяжелом течении болезни, по определенным показаниям.
5) Симптоматическая терапия:
— при температуре – жаропонижающие (парацетамол, нурофен и др);
— при болевом синдроме назначаются спазмолитики (спазган, брал, баралгин и прочие),
— при тошноте и рвота вводят церукал, церуглан;
7) Специфическая терапия (противовирусный и иммуномодулирующий эффект): виразол, специфический иммуноглобулин, амиксин, йодантипирин – все препараты назначаются в первые 3-5 дней болезни.Выписка производится при полном клиническом улучшении, но не ранее 3-4 недели болезни.
Стадии геморрагической лихорадки
Стадии геморрагической лихорадке характеризует механизм развития заболевания в тот или иной период. Все виды лихорадок проходят одни и те же стадии патологического процесса, отличаясь друг от друга лишь своей продолжительностью.
Первая стадия – инкубационный период, который длится в зависимости от вида геморрагической лихорадки от 1 до 3 недель. Затем наступает период начальных проявлений, продолжительностью от 2 дней до недели. Такая стадия имеет неспецифические проявления заболевания. Далее заболевание проявляется периодом разгара (1 — 2 недели). В течение этой стадии возможно формирование осложнений заболевания.
После наступает восстановительный период, или стадия реконвалесценции. Продолжительность данной стадии зависит от вида лихорадки и тяжести течения заболевания. Но минимум она составляет 1 неделю.
Лечение геморрагической лихорадки
Диагностикой и лечением занимаются врачи-инфекционисты, а иногда и реаниматологи.
Все люди с подозрением на геморрагическую лихорадку подлежат госпитализации в боксированное отделение инфекционной больницы.
В период острых проявлений показано парентеральное питание, в период выздоровления – легкая растительно-молочная диета с обогащением витаминами, особенно укрепляющими сосудистые стенки – витаминами РР, С или К.
Кроме того, применяют внутривенные вливания растворов глюкозы, переливания крови, препараты железа, антигистаминные средства. При необходимости вводят тромбоцитарную массу, факторы свертывания.
Постельный режим в изоляторе соблюдается до полного выздоровления. В дальнейшем пациент наблюдается еще достаточно длительно у инфекциониста и терапевта.
Методы диагностики
Диагностика заболевания основана на тщательном сборе анамнеза, осмотре пациента и лабораторных данных
При беседе с пациентом важно уточнять место, где он находился в ближайшее время. По локализации можно оценить эпидемическую ситуацию в районе
Также необходимо уточнить имел ли место контакт с животными или инфицированными людьми.
Анализы крови
В зависимости от вида лихорадки лабораторные данные могут быть различными.
Но для большинства характерны особенности в анализах крови:
- снижение количества лейкоцитов и тромбоцитов в общем анализе крови;
- снижение концентрации гемоглобина;
- повышение скорости оседания эритроцитов;
- изменения в коагулограмме (повышение протромбинового индекса и активированного частичного тромбопластинового времени).
Посевы
Для установки правильного диагноза требуется посев мочи, крови для определения возбудителя заболевания. Также для выявления вируса используют специальные методы: полимеразная цепная реакция, выявление антител и рост их титра. Для определения функции различных органов требуется динамический контроль за их состоянием при помощи инструментальной диагностики.
Виды и общие черты лихорадок, переносимых комарами
Вирусные геморрагические лихорадки – заболевания, возбудителей которых переносят кровососущие насекомые (в основном различные виды комаров и клещей). В основном эти болезни бытуют среди жителей регионов с тропическим и субтропическим климатом, так как именно там температура и влажность оптимальны для существования, размножения и развития насекомых.
К вирусным комариным лихорадкам относится около 30 заболеваний. Наиболее значимыми по риску возникновения крупных вспышек, тяжелому течению и широкой распространенности считаются:
- лихорадка Денге;
- желтая лихорадка;
- лихорадка Зика;
- Чикунгунья;
- лихорадка Западного Нила.
Заражение
Основные симптомы геморрагической лихорадки, наблюдаемые в подавляющем большинстве случаев заболевания:
- высокая температура;
- периодические приступы лихорадки;
- проявления общей интоксикации;
- кровоизлияния на коже или в тканях внутренних органов.
Лечение всех видов геморрагической лихорадки симптоматическое, огромное значение имеет профилактика.
Эпидемиология
Циркуляция вируса в естественных природных очагах осуществляется между лемурами, обезьянами, белками и летучими мышами. Естественным переносчиком вируса являются комары рода Aedes.
Природные очаги сосредоточены в тропических и субтропических регионах Америки, Африки, Южной и Юго-Восточной Азии, Океании и Австралии.
Механизм передачи – трансмиссивный.
В период эпидемии лихорадки главным источником вируса считается больной человек, а переносчик – комары Aedes aegypti и albopictus. У насекомого развивается способность передавать возбудителя спустя 7–12 дней после кровососания больного человека, она сохраняется на протяжении всего жизненного цикла (1–3 месяца). Понижение температуры окружающей среды ниже 22°C приводит к прекращению размножения вируса, поэтому область распространения лихорадки денге ограничена 42° северной и 40° южной долготы.
Эпидемические подъемы заболеваемости в городах и населенных пунктах отличаются массовым характером, их эпицентром наиболее часто бывают школьные и лечебные учреждения. Заболевают преимущественно дети и вновь прибывшие в эндемичный очаг. Иммунитет непродолжительный и типоспецифический. Повторное заражение иными серотипами или наличие врожденного иммунитета, как правило, становится причиной возникновения шокового синдрома денге.
Имеется точка зрения, что к 2050 году лихорадка денге и другие тропические болезни могут распространиться на европейские государства. В зоне наибольшего риска находятся побережье Италии, долина реки По и средиземноморское побережье Испании.
В год на планете заболевает около 50 миллионов человек, смертность от лихорадки денге ежегодно составляет приблизительно 25 тысяч человек.
Что это такое?
Она характеризуется острым началом, двухволновым подъемом температуры тела, выраженной интоксикацией и геморрагическим синдромом (повышенной кровоточивостью).
Болезнь была впервые обнаружена российскими врачами в 1944 году в Крыму, позже сходное заболевание было описано в Конго, Нигерии, Сенегале, Кении.
Возбудителем лихорадки является РНК-содержащий вирус из рода нейровирусов. Его резервуаром в природе являются дикие мелкие млекопитающие, на которых паразитируют иксодовые клещи (заяц-русак, ушастый еж, лесная мышь), переносчиками служат многие виды пастбищных клещей. Сезонность инфекции на юге России — с мая по август.
Больной человек может служить источником инфекции для других, описаны также случаи госпитального заражения при контакте с кровью больных.
Лихорадка Западного Нила
Возбудителем является вирус, к-рый был выделен в 1940 г. в провинции Западный Нил (Уганда) из крови больной женщины. Имеются сообщения о выделении вируса от людей, птиц и членистоногих в Египте, Израиле, Нигерии, Сенегале, Судане, Заире, Эфиопии, странах Южной Африки, во Франции (дельта Роны), Индии, Пакистане, в Советском Союзе (дельта Волги, Азербайджан, Средняя Азия). Штаммы вируса, выделенные в разных географических районах, имеют антигенные различия, выявляемые при постановке реакции торможения гемагглютинации (см. Вирусологические исследования).
Источником возбудителей инфекции являются птицы, у к-рых она протекает бессимптомно. Из домашних животных к вирусу наиболее чувствительны лошади; в циркуляции вируса, возможно, участвуют коровы, буйволы, овцы, свиньи, утки и куры. Переносчиками вируса являются комары рода Culex и Mansonia. Зимой вирус может сохраняться в организме птиц и комаров. В Египте вирус выделяли от клещей Argas reflexus hermanni, в дельте Волги — Hyalomma plumbeum, в Азербайджане — Ornithodoros со-niceps.
В эндемических р-нах Африки болеют преимущественно дети, у к-рых развивается стойкий иммунитет к последующему заражению. В нек-рых районах Египта антитела к вирусу обнаруживают у 60—70% обследованных лиц. У населения южной полосы умеренной зоны Евразии частота выявления антител невелика; в Астраханской области этот показатель колеблется от 10 до 15%, а в разных р-нах Средней Азии от 1 до 19%. Несмотря на широкое распространение вируса, в конце 60-х гг. 20 в. зарегистрированы лишь единичные эпидемические вспышки в ЮАР, Израиле в связи с одновременным прибытием в эндемический очаг большого числа неиммунных переселенцев.
Инкубационный период 4—12 дней. Лихорадочный период продолжается от 1 до 7 дней. Температурная кривая в типичных случаях имеет два пика. Больные жалуются на усталость, боли в мышцах и суставах, иногда на головные боли и на боли в животе. Возможны конъюнктивит, кашель, насморк. На коже появляется петехиальная или макулопапулезная, иногда везикулезная сыпь, исчезающая при нормализации температуры. Клин, проявления существенно варьируют в зависимости от возраста. Дети, как правило, переболевают бессимптомной или стертой формой инфекции; у них лишь изредка отмечаются лихорадка, боли в суставах, увеличение лимф, узлов, сыпь, лейкопения. У лиц пожилого возраста чаще отмечаются менингит, менингоэнцефалит и энцефалит. В этом случае на фоне внезапного подъема температуры появляются признаки нарушения сознания, симптомы поражения мозговых оболочек, пирамидных путей, сильные головные боли. В цереброспинальной жидкости выявляют увеличение белка и плеоцитоз, гл. обр. за счет лимфоцитов.
Поставить диагноз только на основании клин, картины трудно. Предполагать заболевание можно в очагах, где доказана циркуляция вируса, а также и в тех случаях, когда в период активности комаров — переносчиков вируса — выявляют больных с лихорадкой, сопровождающейся сыпью. Окончательный диагноз устанавливают только на основании результатов вирусол. исследования.
Дифференциальную диагностику проводят с помощью лаб. исследований, в первую очередь, с денге (см.) и лихорадкой Синдбис.
Как правило, заболевание заканчивается полным выздоровлением. При поражении ц. н. с. регистрируются единичные летальные исходы.
Передача инфекции
Передача при укусах комаров
Вирус передается человеку, когда его кусает инфицированная самка комара, в основном Aedes aegypti. Другие виды из рода Aedes могут также быть переносчиками инфекции, но в меньшей степени, чем Aedes aegypti.
Вирус попадает в организм комара, когда комар кусает зараженного DENV человека, после чего размножается в среднем кишечнике комара, а затем распространяется во вторичные ткани, включая слюнные железы. Период времени с момента попадания вируса в организм
комара до его фактической передачи новому хозяину называется внешним инкубационным периодом (ВИП). При температуре окружающей среды в пределах 25–28°C ВИП составляет около 8–12 дней . На длительность
внешнего инкубационного периода влияет не только температура окружающей среды; время, необходимое комару для передачи вируса, может также меняться под воздействием ряда других факторов, таких как диапазон суточных температурных колебаний ,
генотип вируса и начальная концентрация вируса . После инфицирования комар способен передавать вирус в течение всей оставшейся жизни.
Передача инфекции от человека комару
Комары могут инфицироваться от людей, зараженных DENV. Ими могут быть лица с симптоматической инфекцией денге, лица, у которых пока еще нет симптоматической инфекции (предсимптомные пациенты), а также лица, у которых нет никаких признаков болезни (бессимптомные
пациенты)
.
Передача вируса от человека комару возможна в период от двух дней перед появлением симптомов заболевания у человека до истечения двух дней после окончания лихорадки .
Риск инфицирования комара находится в положительной корреляции с высоким уровнем виремии и высокой температурой у пациента; и наоборот, высокие уровни DENV-специфических антител связаны со сниженным риском инфицирования комара (Nguyen et al 2013 PNAS).
Большинство людей остаются заразными в течение примерно четырех–пяти дней, но виремия может длиться до 12 дней .
Передача от матери ребенку
Основными переносчиками DENV среди людей являются комары. Вместе с тем имеются фактические данные, свидетельствующие о возможной передаче инфекции от матери (от беременной женщины ее ребенку). Показатели вертикальной передачи инфекции представляются низкими,
но при этом ее риск, по-видимому, связан с тем, на каком сроке беременности происходит инфицирование денге . Дети матерей, инфицированных DENV во время беременности, могут страдать недоношенностью, низкой массой тела при
рождении и дистресс-синдромом плода .
Другие пути передачи
Зарегистрированы редкие случаи передачи вируса с продуктами крови, при донорстве органов и переливании крови. Также отмечаются случаи трансовариальной передачи вируса в популяциях комаров.
Характерные особенности, признаки и симптомы лихорадки Зика
Лихорадка Зика – острое инфекционное заболевание. Его возбудитель – вирус Зика, принадлежащий к роду Flavivirus. В основном болезнь провоцируют укусы комаров, обитающих в Африке, Южной Америке и Океании.
Достаточно часто болезнь протекает бессимптомно. Инкубационный период длится от 3 до 15 дней.
Наиболее частые симптомы лихорадки Зика:
- высокая температура (держится на протяжении нескольких дней);
- слабость, сонливость;
- зудящая сыпь, которая появляется на лице, туловище, постепенно занимая все большие участки тела;
- мышечные и суставные боли;
- конъюнктивит (примерно у половины пациентов).
Отличие симптомов лихорадки Зика от других типов заболевания – относительно слабо выраженная интоксикация.
Что провоцирует / Причины Лихорадки Денге:
Возбудители денге относятся к вирусам семейства Togaviridae рода Flavivirus (арбовирусы антигенной группы В). Содержат РНК, имеют двухслойную липидную оболочку из фосфолипидов и холестерола, размеры вириона 40-45 нм в диаметре. Инактивируется при обработке протеолитическими ферментами и при прогревании выше 60°С, под влиянием ультрафиолетового облучения. Известно 4 типа вируса денге, различных в антигенном отношении. Вирусы денге имеют антигенное родство с вирусами желтой лихорадки, японского и западно-нильского энцефалитов. Размножается на культурах тканей и клетках почек обезьян, хомяков, KB и др. В сыворотке крови больных вирус сохраняется при комнатной температуре до 2 мес, а высушенный – до 5 лет.
За последние 10-15 лет наблюдается значительное повышение заболеваемости в различных регионах. Сообщалось о значительных вспышках денге в Китайской Народной Республике, Вьетнаме, Индонезии, Таиланде и на Кубе. Во время вспышки на Кубе в 1981 г. лихорадка денге наблюдалась почти у 350 000 человек, около 10 000 из них болели более тяжелой геморрагической формой, умерло 158 больных (смертность 1,6%). В Китайской Народной Республике во время эпидемии 1980 г. заболело 437 468 человек (умерло 54). Во время эпидемической вспышки 1985-1986 гг. заболело 113 589 человек (умерло 289). Причины подъема заболеваемости остаются неясными, несмотря на большой интерес к проблеме лихорадки денге (за период 1983-1988 гг. в периодической печати было опубликовано 777 работ, кроме того, проблема денге рассматривалась в 136 книгах).
Источником инфекции служат больной человек, обезьяны и, возможно, летучие мыши.
Передача инфекции у человека осуществляется комарами Aedes aegypti, у обезьян – A. albopictus. Комар A. aegypti становится заразным через 8-12 дней после питания кровью больного человека. Комар остается инфицированным до 3 мес и более. Вирус способен развиваться в теле комара лишь при температуре воздуха не ниже 22°С. В связи с этим денге распространена в тропических и субтропических районах (от 42° северной до 40° южной широты). Денге встречается в странах Южной и Юго-Восточной Азии, Океании, Африки, бассейна Карибского моря. Заболевают преимущественно дети, а также вновь прибывшие в эндемичный район лица.
Естественная восприимчивость людей высокая, чаше болеют дети и лица, приехавшие в эндемичные районы. Постинфекционный иммунитет типоспецифичный, стойкий и длится несколько лет. Повторные заболевания возможны по истечении этого времени или при инфицировании вирусом иного типа.
Характеристика возбудителя
Возбудителем лихорадки Зика является арбовирус семейства Flaviviridae рода Flavivirus (Zika virus, ZIKV). Впервые выделен в 1947 году от макак-резусов, обитающих в лесу Зика (Уганда). Годом позже вирус был выделен из организма самки комара рода Aedes aegipti, в 1968 году — из биоматериала инфицированных представителей коренного населения Нигерии. В 1952 году было выявлено, что возбудители способны поселятся в тканях мозга мышей, вызывая размягчение мозга и дегенерацию нейронов.
Вирус Зика имеет сферическую форму, диаметр около 50 нм. Оболочка гликопротеиновая. Поверхностные белки располагаются в виде иксоаэдра. Нуклеокапсид содержит одноцепочечную линейную РНК, содержащую 10 794 нуклеотида, которые кодируют 3419 аминокислот. Обладает высокой способностью к мутациям.
Рис. 3. Вирус Зика под микроскопом.
Что происходит?
Вирус проникает в организм человека через кожу (при укусах клещей), накапливается в клетках ретикулоэндотелиальной системы, циркулирует в крови. Инкубационный период составляет от 1 до 14 дней (чаще 2-7). Болезнь начинается остро, с резкого повышения температуры тела до 39-40°С, сопровождающегося ознобом.
Отмечается резко выраженная головная боль, слабость, сонливость, боли в мышцах и суставах, рези в животе, иногда сопровождаемые рвотой. При осмотре больных в начальном периоде отмечается выраженное покраснение кожи лица, шеи и верхних отделов грудной клетки («симптом капюшона»).
Вирус поражает эндотелий сосудов, а также кору надпочечников и гипоталамус, что в итоге приводит к повышению проницаемости сосудистой стенки, нарушению процессов свертывания крови. Ко 2-6 дням болезни развивается геморрагический синдром. Одновременно с небольшим снижением температуры на боковых поверхностях грудной клетки, в области плечевого пояса, на верхних и нижних конечностях появляется обильная геморрагическая сыпь.
Отмечаются обширные кровоизлияния в местах инъекций, носовые кровотечения, кровоточивость десен. Тяжесть заболевания в этот период нарастает, возможны эпизоды потери сознания. Желудочные и кишечные кровотечения ухудшают прогноз.
В среднем температура остается повышенной в течение 12 дней, выздоровление проходит медленно, повышенная слабость и утомляемость (астения) сохраняется в течение 1-2 месяцев. К летальному исходу могут приводить осложнения, такие как отек легких, сепсис, острая почечная недостаточность, пневмония.
Исторические данные геморрагической лихорадки
Первые случаи крымской геморрагической лихорадки выявлены в степных районах Крымской области летом 1944 г. среди населения, занятого на сенокосе и уборке урожая. Впервые подробно изучили клинику и эпидемиологии болезни А. А. Колачов, Я. К. Гимельфарб, 1. Р. Дробинський, В. М. Домрачева. Болезнь получила предварительное название «острый инфекционный капилляротоксикоз». Экспедиция во главе с академиком М. П. Чумаковым в 1944-1945 pp. установила вирусную этиологию болезни.
Эпидемиология. Резервуаром вируса являются дикие мелкие млекопитающие: лесная мышь, малый суслик, заяц-русак, ушастый еж. Переносчиком и хранителем являются клещи, преимущественно из рода Hyalomma.
Самка клеща рода Hyalomma – переносчик заболевания.
Заболеваемость характеризуется сезонностью с максимумом с мая по август (в нашей стране). Болезнь наблюдалась в Крыму, Астраханской, Ростовской областях, Краснодарском и Ставропольском краях, а также в Средней Азии, Китае, Болгарии, Югославии, в большинстве стран Африки к югу от Сахары (Конго, Кения, Уганда, Нигерия и др.). В 80% случаев заболевают.
Глобальное бремя болезни
За последние десятилетия заболеваемость денге в мире резко возросла. У подавляющего большинства зараженных инфекция протекает бессимптомно или в легкой форме и без обращения за медицинской помощью, и поэтому реально происходящие случаи заболевания
регистрируются не в полной мере. Кроме того, часто денге принимают за другие лихорадочные заболевания .
По данным одной модели, ежегодно происходит 390 млн случаев инфицирования вирусом денге (95%-ный доверительный интервал составляет 284–528 млн), из которых 96 млн (67–136 млн) проявляются клинически (с любой степенью тяжести
заболевания)
. Согласно данным другого исследования по вопросу о распространенности денге, риску инфицирования вирусами денге подвергаются 3,9 млн человек. Несмотря на то что риск инфицирования существует в 129 странах ,
70% фактического бремени болезни приходится на Азию .
За последние два десятилетия численность случаев денге, о которых получает уведомления ВОЗ, возросла более чем в восемь раз – с 505 430 случаев в 2000 г. до более чем 2,4 млн в 2010 г. и 5,2 млн в 2019 г. Число
зарегистрированных случаев смерти за период с 2000 по 2015 г. выросло с 960 до 4032; смертность в основном приходится на более молодые возрастные группы. В 2020–2021 гг. общая численность случаев заболевания, а также регистрируемых
случаев смерти, по всей видимости, снизилась. Вместе с тем имеющиеся данные пока имеют неполный характер, а в некоторых странах пандемия COVID-19 могла препятствовать регистрации случаев.
Преобладающая общая тенденция к росту заболеваемости в последние два десятилетия отчасти объясняется изменением национальных методик регистрации случаев и представления отчетности по денге министерствам здравоохранения и ВОЗ
Но это также свидетельствует
и о том, что правительства признают бремя денге и, следовательно, важность представления отчетности в отношении этого бремени





































